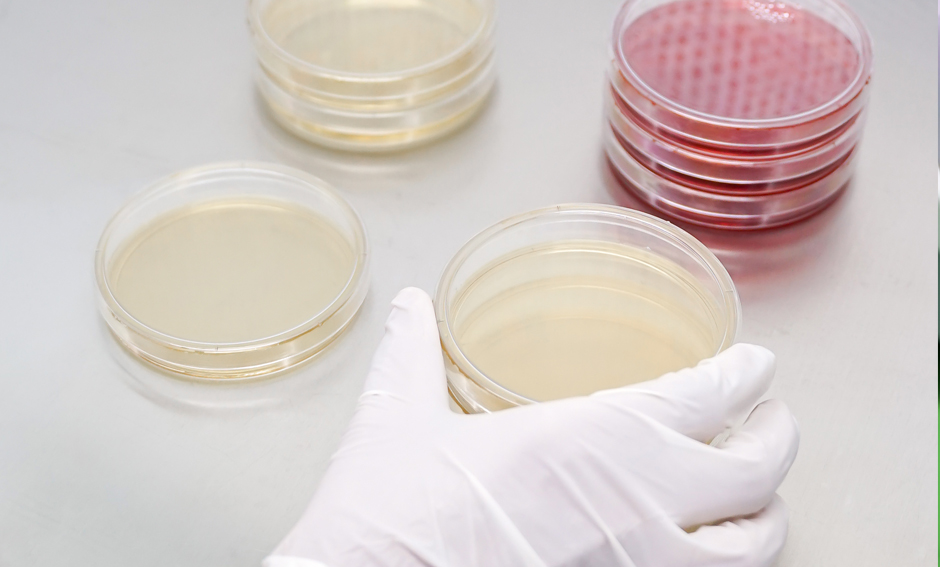
Portfolio Item

Loading...
Harga Kompetitif
Hasil Produksi kami sangat terjamin, Sehingga Anda dapat menghemat uang Anda dengan memilih kami dan Layanan kami terjamin.Ciptakan Produk Anda
Semuanya didesain sesuai yang Anda inginkan. Mulai dari ide, produk, desain kemasan dan merek itu sendiri.Kualitas Terjamin
BSB memiliki layanan produksi dan Team yang sudah berpengalaman dalam bidang produksi Minuman serbuk.Bersertifikat
Bisnis kami sudah memiliki sertifikat dan terdaftar di BPOMAbout Us
PT Belleea Sumber Berkat pilihan tepat karena kualitas produk yang dihasilkan sangat terjamin. Kami memiliki tim R&D yang terdiri dari para ahli Minuman Serbuk yang berpengalaman lebih dari puluhan tahun dan
memiliki pengetahuan yang luas tentang Minuman Serbuk. Dengan demikian, produk Minuman Serbuk yang dihasilkan oleh PT Belleea Sumber Berkat
dapat memberikan kualitas yang baik.
PT Belleea Sumber Berkat adalah mitra maklon Minuman serbuk yang terpercaya. Kami menjamin kualitas dan keamanan produk terbaik untuk Anda. Dengan sertifikasi BPOM, produk Anda dipastikan aman dan sesuai standar regulasi. Percayakan pada kami untuk mewujudkan produk Minuman serbuk yang aman, berkualitas, dan sukses di pasaran.
Our Picture
Want to see more works?
We are always open to interesting projects.
Our Product
Ciptakan Produk Anda Semuanya didesain sesuai yang Anda inginkan. Mulai dari ide, produk, desain kemasan dan merek itu sendiri.
Coffee
Minuman Serbuk
Sereal Drink
Minuman Serbuk
Fiber Drink
Minuman Serbuk
Frequently Asked Questions (FAQ)
JL. RAYA PREPEDAN. 198. BLOK AD. KEC. KALIDERES, BARAT, KEL, KAMAL, Kota Jakarta Barat, Daerah Khusus Ibukota Jakarta 11810
Pembuatan Sample Produk gratis tidak di pungut biaya apapun, anda tinggal menghubungi team marketing kami di 081 2222 39106 dan team Marketing kami akan siap membantu anda
PT Belleea Sumber Berkat memproduksi Minuman serbuk kopi, Sereal, Fiber, Kolagen dan Susu kami juga memproduksi Obat tradisional seperti Cairan Obat Dalam
dan Kapsul.
Maklon adalah kegiatan manufaktur di mana seseorang atau perusahaan (pemilik merek) menggunakan jasa pihak ketiga untuk memproduksi barang dagangannya. Dalam model bisnis maklon, pemilik merek menyediakan spesifikasi, desain, atau formula, sementara perusahaan maklon menyediakan fasilitas pabrik, tenaga kerja, dan proses produksi hingga barang jadi.